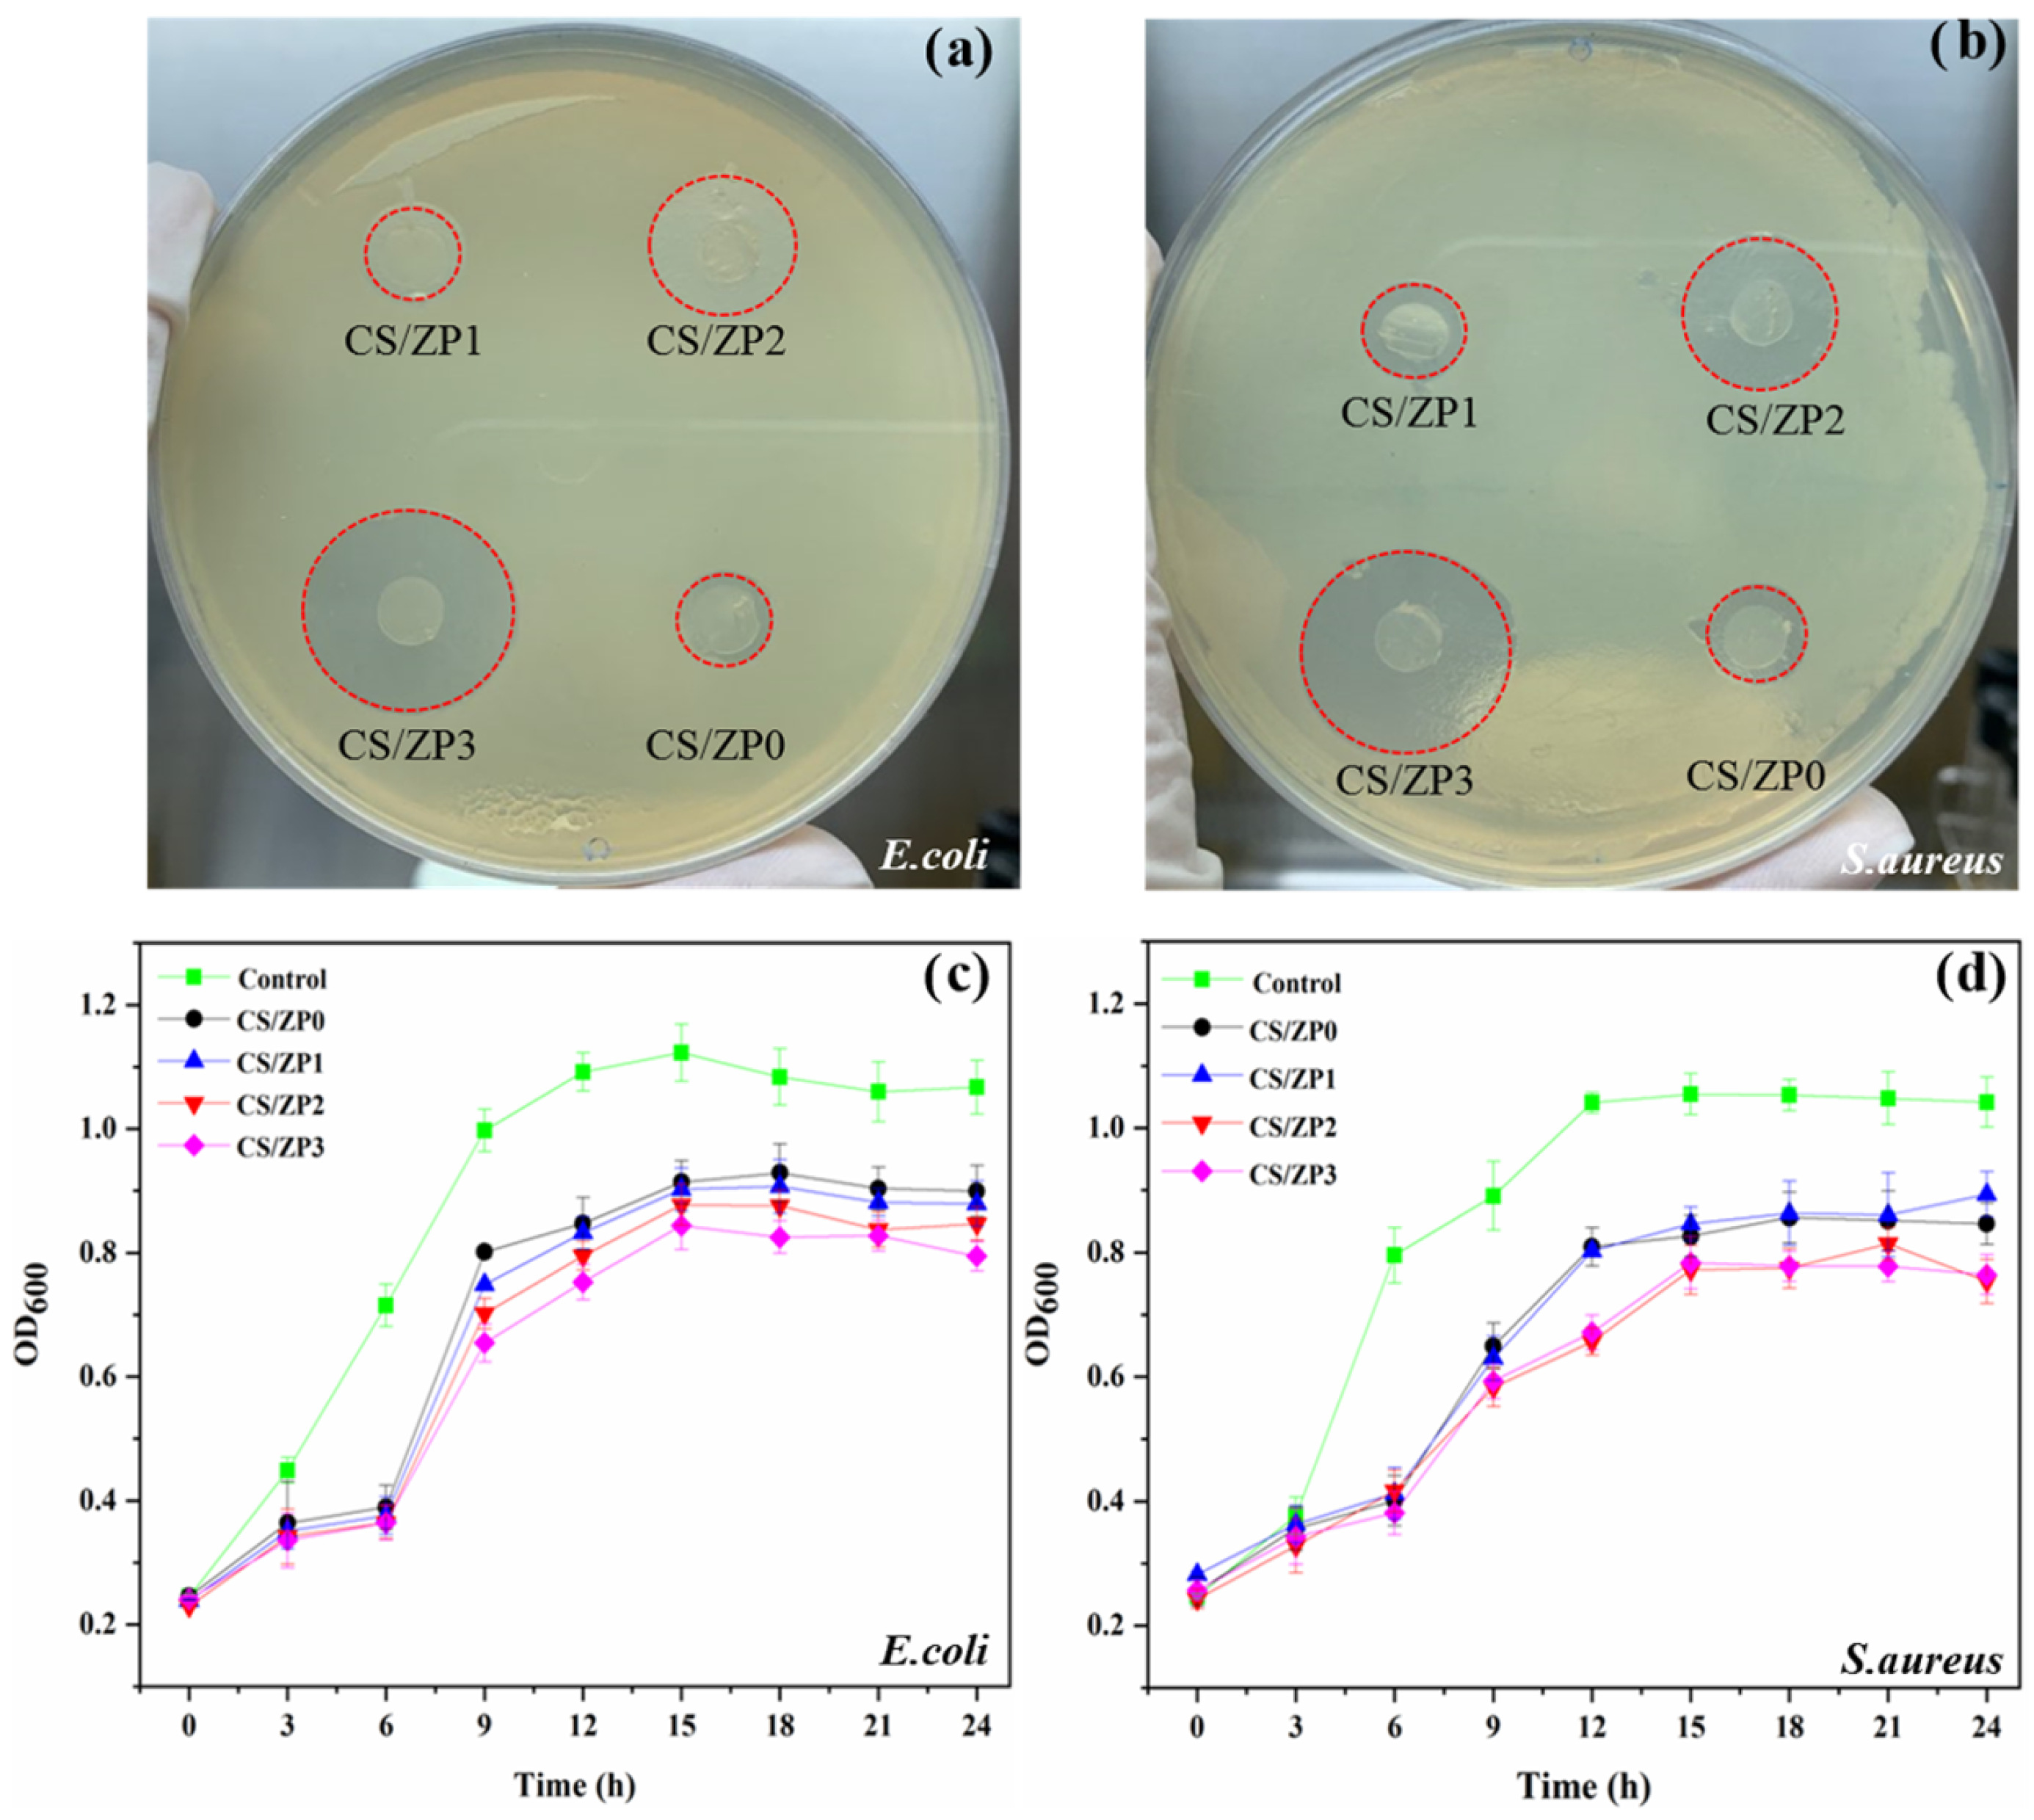
Polymers 13 00425 g007

Investigation of Functionalized Surface Charges of Thermoplastic Starch/Zinc Oxide Nanocomposite Films Using Polyaniline: The Potential of Improved Antibacterial Properties
Abstract
1. Introduction
2. Materials and Methods
2.1. Materials
2.2. ZnO and Functionalized ZnO NP Synthesis and Characterization
2.3. Preparation of Bionanocomposite Film and Characterization
2.4. Functional Properties of Bionanocomposite Film Analysis
2.5. Antibacterial Activity
3. Results and Discussions
3.1. ZnO and Functionalized ZnO NP Characterization
3.2. Bionanocomposite Films Characterization
3.3. Functional and Water Susceptibility of Bionanocomposite Films
3.4. Mechanical Properties of Bionanocomposite Films
3.5. Thermal Properties of Bionanocomposite Films
3.6. Antibacterial Activity
4. Conclusions
Author Contributions
Funding
Institutional Review Board Statement
Informed Consent Statement
Data Availability Statement
Acknowledgments
Conflicts of Interest
References
- Dai, X.; Guo, Q.; Zhao, Y.; Zhang, P.; Zhang, T.; Zhang, X.; Li, C. Functional silver nanoparticle as a benign antimicrobial agent that eradicates antibiotic-resistant bacteria and promotes wound healing. ACS Appl. Mater. Interfaces 2016, 8, 25798–25807. [Google Scholar] [CrossRef] [PubMed]
- Cao, Y.; Naseri, M.; He, Y.; Xu, C.; Walsh, L.J.; Ziora, Z.M. Non-antibiotic antimicrobial agents to combat biofilm-forming bacteria. J. Glob. Antimicrob. Resist. 2019. [Google Scholar] [CrossRef] [PubMed]
- Xanthos, D.; Walker, T.R. International policies to reduce plastic marine pollution from single-use plastics (plastic bags and microbeads): A review. Mar. Pollut. Bull. 2017, 118, 17–26. [Google Scholar] [CrossRef] [PubMed]
- Tang, S.; Wang, Z.; Li, W.; Li, M.; Deng, Q.; Wang, Y.; Li, C.; Chu, P.K. Ecofriendly and biodegradable soybean protein isolate films incorporated with zno nanoparticles for food packaging. ACS Appl. Bio Mater. 2019, 2, 2202–2207. [Google Scholar] [CrossRef]
- Kuswandi, B. Nanotechnology in food packaging. In Nanoscience in Food and Agriculture 1; Springer: Cham, Switzerland, 2016; pp. 151–183. [Google Scholar]
- Wohner, B.; Pauer, E.; Heinrich, V.; Tacker, M. Packaging-related food losses and waste: An overview of drivers and issues. Sustainability 2019, 11, 264. [Google Scholar] [CrossRef]
- Mirjalili, F.; Yassini Ardekani, A. Preparation and characterization of starch film accompanied with ZnO nanoparticles. J. Food Process Eng. 2017, 40, e12561. [Google Scholar] [CrossRef]
- Peighambardoust, S.J.; Peighambardoust, S.H.; Pournasir, N.; Pakdel, P.M. Properties of active starch-based films incorporating a combination of Ag, ZnO and CuO nanoparticles for potential use in food packaging applications. Food Packag. Shelf Life 2019, 22, 100420. [Google Scholar] [CrossRef]
- Veluswamy, P.; Sathiyamoorthy, S.; Chowdary, K.H.; Muthusamy, O.; Krishnamoorthy, K.; Takeuchi, T.; Ikeda, H. Morphology dependent thermal conductivity of ZnO nanostructures prepared via a green approach. J. Alloys Compd. 2017, 695, 888–894. [Google Scholar] [CrossRef]
- Barui, A.K.; Kotcherlakota, R.; Patra, C.R. Biomedical applications of zinc oxide nanoparticles. In Inorganic Frameworks as Smart Nanomedicines; Elsevier: Amsterdam, The Netherlands, 2018; pp. 239–278. [Google Scholar]
- Otoni, C.G.; Espitia, P.J.; Avena-Bustillos, R.J.; McHugh, T.H. Trends in antimicrobial food packaging systems: Emitting sachets and absorbent pads. Food Res. Int. 2016, 83, 60–73. [Google Scholar] [CrossRef]
- Bumbudsanpharoke, N.; Choi, J.; Park, H.J.; Ko, S. Zinc migration and its effect on the functionality of a low density polyethylene-ZnO nanocomposite film. Food Packag. Shelf Life 2019, 20, 100301. [Google Scholar] [CrossRef]
- Kanmani, P.; Rhim, J.W. Properties and characterization of bionanocomposite films prepared with various biopolymers and ZnO nanoparticles. Carbohydr. Polym. 2014, 106, 190–199. [Google Scholar] [CrossRef] [PubMed]
- Cai, X.; Luo, Y.; Zhang, W.; Du, D.; Lin, Y. pH-Sensitive ZnO quantum dots–doxorubicin nanoparticles for lung cancer targeted drug delivery. ACS Appl. Mater. Interfaces 2016, 8, 22442–22450. [Google Scholar] [CrossRef] [PubMed]
- Prabha, S.; Durgalakshmi, D.; Subramani, K.; Aruna, P.; Ganesan, S. Enhanced Emission of Zinc Nitride Colloidal Nanoparticles with Organic Dyes for Optical Sensors and Imaging Application. ACS Appl. Mater. Interfaces 2020, 12, 19245–19257. [Google Scholar] [CrossRef] [PubMed]
- Selegård, L.; Khranovskyy, V.; Soderlind, F.; Vahlberg, C.; Ahrén, M.; Kall, P.O.; Yakimova, R.; Uvdal, K. Biotinylation of ZnO nanoparticles and thin films: A two-step surface functionalization study. ACS Appl. Mater. Interfaces 2010, 2, 2128–2135. [Google Scholar] [CrossRef] [PubMed]
- Wang, J.; Lee, J.S.; Kim, D.; Zhu, L. Exploration of zinc oxide nanoparticles as a multitarget and multifunctional anticancer nanomedicine. ACS Appl. Mater. Interfaces 2017, 9, 39971–39984. [Google Scholar] [CrossRef]
- Jayakumar, A.; Heera, K.; Sumi, T.; Joseph, M.; Mathew, S.; Praveen, G.; Nair, I.C.; Radhakrishnan, E. Starch-PVA composite films with zinc-oxide nanoparticles and phytochemicals as intelligent pH sensing wraps for food packaging application. Int. J. Biol. Macromol. 2019, 136, 395–403. [Google Scholar] [CrossRef]
- Rahman, P.M.; Mujeeb, V.A.; Muraleedharan, K.; Thomas, S.K. Chitosan/nano ZnO composite films: Enhanced mechanical, antimicrobial and dielectric properties. Arab. J. Chem. 2018, 11, 120–127. [Google Scholar] [CrossRef]
- Kim, K.M.; Choi, M.H.; Lee, J.K.; Jeong, J.; Kim, Y.R.; Kim, M.K.; Paek, S.M.; Oh, J.M. Physicochemical properties of surface charge-modified ZnO nanoparticles with different particle sizes. Int. J. Nanomed. 2014, 9, 41. [Google Scholar]
- Cho, S.; Jang, J.W.; Jung, S.H.; Lee, B.R.; Oh, E.; Lee, K.H. Precursor effects of citric acid and citrates on ZnO crystal formation. Langmuir 2009, 25, 3825–3831. [Google Scholar] [CrossRef]
- Indubala, E.; Dhanasekar, M.; Sudha, V.; Malar, E.P.; Divya, P.; Sherine, J.; Rajagopal, R.; Bhat, S.V.; Harinipriya, S. L-Alanine capping of ZnO nanorods: Increased carrier concentration in ZnO/CuI heterojunction diode. RSC Adv. 2018, 8, 5350–5361. [Google Scholar] [CrossRef]
- Kim, I.; Viswanathan, K.; Kasi, G.; Sadeghi, K.; Thanakkasaranee, S.; Seo, J. Poly (lactic acid)/ZnO bionanocomposite films with positively charged ZnO as potential antimicrobial food packaging materials. Polymers 2019, 11, 1427. [Google Scholar] [CrossRef] [PubMed]
- Rodwihok, C.; Wongratanaphisan, D.; Tam, T.V.; Choi, W.M.; Hur, S.H.; Chung, J.S. Cerium-Oxide-Nanoparticle-Decorated Zinc Oxide with Enhanced Photocatalytic Degradation of Methyl Orange. Appl. Sci. 2020, 10, 1697. [Google Scholar] [CrossRef]
- Vijayalakshmi, K.; Sivaraj, D. Enhanced antibacterial activity of Cr doped ZnO nanorods synthesized using microwave processing. RSC Adv. 2015, 5, 68461–68469. [Google Scholar] [CrossRef]
- Qi, K.; Cheng, B.; Yu, J.; Ho, W. Review on the improvement of the photocatalytic and antibacterial activities of ZnO. J. Alloys Compd. 2017, 727, 792–820. [Google Scholar] [CrossRef]
- Wang, J.; Zhou, H.; Guo, G.; Tan, J.; Wang, Q.; Tang, J.; Liu, W.; Shen, H.; Li, J.; Zhang, X. Enhanced anti-infective efficacy of ZnO nanoreservoirs through a combination of intrinsic anti-biofilm activity and reinforced innate defense. ACS Appl. Mater. Interfaces 2017, 9, 33609–33623. [Google Scholar] [CrossRef]
- Jiang, T.; Duan, Q.; Zhu, J.; Liu, H.; Yu, L. Starch-based biodegradable materials: Challenges and opportunities. Adv. Ind. Eng. Polym. Res. 2020, 3, 8–18. [Google Scholar] [CrossRef]
- Soe, M.T.; Chitropas, P.; Pongjanyakul, T.; Limpongsa, E.; Jaipakdee, N. Thai glutinous rice starch modified by ball milling and its application as a mucoadhesive polymer. Carbohydr. Polym. 2020, 232, 115812. [Google Scholar] [CrossRef]
- Herniou, C.; Mendieta, J.R.; Gutiérrez, T.J. Characterization of biodegradable/non-compostable films made from cellulose acetate/corn starch blends processed under reactive extrusion conditions. Food Hydrocoll. 2019, 89, 67–79. [Google Scholar] [CrossRef]
- Mendes, J.; Paschoalin, R.; Carmona, V.; Neto, A.R.S.; Marques, A.; Marconcini, J.; Mattoso, L.; Medeiros, E.; Oliveira, J. Biodegradable polymer blends based on corn starch and thermoplastic chitosan processed by extrusion. Carbohydr. Polym. 2016, 137, 452–458. [Google Scholar] [CrossRef]
- Stading, M.; Hermansson, A.M.; Gatenholm, P. Structure, mechanical and barrier properties of amylose and amylopectin films. Carbohydr. Polym. 1998, 36, 217–224. [Google Scholar]
- Marichelvam, M.; Jawaid, M.; Asim, M. Corn and rice starch-based bio-plastics as alternative packaging materials. Fibers 2019, 7, 32. [Google Scholar] [CrossRef]
- Ribba, L.; Garcia, N.L.; D’Accorso, N.; Goyanes, S. Disadvantages of starch-based materials, feasible alternatives in order to overcome these limitations. In Starch-Based Materials in Food Packaging; Elsevier: Amsterdam, The Netherlands, 2017; pp. 37–76. [Google Scholar]
- Jiménez, A.; Fabra, M.J.; Talens, P.; Chiralt, A. Edible and biodegradable starch films: A review. Food Bioprocess Technol. 2012, 5, 2058–2076. [Google Scholar] [CrossRef]
- Sun, Q.; Xi, T.; Li, Y.; Xiong, L. Characterization of corn starch films reinforced with CaCO3 nanoparticles. PLoS ONE 2014, 9, e106727. [Google Scholar] [CrossRef] [PubMed]
- Rodwihok, C.; Charoensri, K.; Wongratanaphisan, D.; Choi, W.M.; Hur, S.H.; Park, H.J.; Chung, J.S. Improved photocatalytic activity of surface charge functionalized ZnO nanoparticles using aniline. J. Mater. Sci. Technol. 2021, 76, 1–10. [Google Scholar] [CrossRef]
- Lee, S.; Kim, H.; Beuchat, L.R.; Kim, Y.; Ryu, J.H. Synergistic antimicrobial activity of oregano and thyme thymol essential oils against Leuconostoc citreum in a laboratory medium and tomato juice. Food Microbiol. 2020, 90, 103489. [Google Scholar] [CrossRef]
- Rodwihok, C.; Wongratanaphisan, D.; Thi Ngo, Y.L.; Khandelwal, M.; Hur, S.H.; Chung, J.S. Effect of GO additive in ZnO/rGO nanocomposites with enhanced photosensitivity and photocatalytic activity. Nanomaterials 2019, 9, 1441. [Google Scholar] [CrossRef]
- Yu, H.; Xiao, P.; Tian, J.; Wang, F.; Yu, J. Phenylamine-functionalized rGO/TiO2 photocatalysts: Spatially separated adsorption sites and tunable photocatalytic selectivity. ACS Appl. Mater. Interfaces 2016, 8, 29470–29477. [Google Scholar] [CrossRef]
- Chen, Z.; Li, L.; Yao, H.; Guo, L.; Yan, H.; Liu, Q. Improved mechanical and tribological performance of bismaleimide composites with green synthesis of graphene/kapok-like ZnO. Polym. Test. 2018, 68, 77–86. [Google Scholar] [CrossRef]
- Jayalakshmi, G.; Saravanan, K.; Balasubramanian, T. Impact of thiol and amine functionalization on photoluminescence properties of ZnO films. J. Lumin. 2013, 140, 21–25. [Google Scholar] [CrossRef]
- Ievtushenko, A.; Khyzhun, O.; Shtepliuk, I.; Tkach, V.; Lazorenko, V.; Lashkarev, G. X-Ray Photoelectron Spectroscopy Study of Nitrogen and Aluminum-Nitrogen Doped ZnO Films. Acta Phys. Pol. A 2013, 124. [Google Scholar] [CrossRef]
- Rahman, M.M.; Islam, M.S.; Li, G.S. Development of PLA/CS/ZnO nanocomposites and optimization its mechanical, thermal and water absorption properties. Polym. Test. 2018, 68, 302–308. [Google Scholar] [CrossRef]
- Ni, S.; Zhang, H.; Dai, H.; Xiao, H. Starch-based flexible coating for food packaging paper with exceptional hydrophobicity and antimicrobial activity. Polymers 2018, 10, 1260. [Google Scholar] [CrossRef] [PubMed]
- Lopez, O.; Garcia, M.A.; Villar, M.A.; Gentili, A.; Rodriguez, M.; Albertengo, L. Thermo-compression of biodegradable thermoplastic corn starch films containing chitin and chitosan. LWT-Food Sci. Technol. 2014, 57, 106–115. [Google Scholar] [CrossRef]
- Alias, S.; Ismail, A.; Mohamad, A. Effect of pH on ZnO nanoparticle properties synthesized by sol–gel centrifugation. J. Alloys Compd. 2010, 499, 231–237. [Google Scholar] [CrossRef]
- Arfat, Y.A.; Benjakul, S.; Prodpran, T.; Sumpavapol, P.; Songtipya, P. Properties and antimicrobial activity of fish protein isolate/fish skin gelatin film containing basil leaf essential oil and zinc oxide nanoparticles. Food Hydrocoll. 2014, 41, 265–273. [Google Scholar] [CrossRef]
- Estevez-Areco, S.; Guz, L.; Candal, R.; Goyanes, S. Active bilayer films based on cassava starch incorporating ZnO nanorods and PVA electrospun mats containing rosemary extract. Food Hydrocoll. 2020, 108, 106054. [Google Scholar] [CrossRef]
- Vaezi, K.; Asadpour, G.; Sharifi, H. Effect of ZnO nanoparticles on the mechanical, barrier and optical properties of thermoplastic cationic starch/montmorillonite biodegradable films. Int. J. Biol. Macromol. 2019, 124, 519–529. [Google Scholar] [CrossRef]
- Sani, I.K.; Pirsa, S.; Tağı, Ş. Preparation of chitosan/zinc oxide/Melissa officinalis essential oil nano-composite film and evaluation of physical, mechanical and antimicrobial properties by response surface method. Polym. Test. 2019, 79, 106004. [Google Scholar] [CrossRef]
- Wang, X.; Tang, Y.; Zhu, X.; Zhou, Y.; Hong, X. Preparation and characterization of polylactic acid/polyaniline/nanocrystalline cellulose nanocomposite films. Int. J. Biol. Macromol. 2020, 146, 1069–1075. [Google Scholar] [CrossRef]
- Menzel, C.; González-Martínez, C.; Chiralt, A.; Vilaplana, F. Antioxidant starch films containing sunflower hull extracts. Carbohydr. Polym. 2019, 214, 142–151. [Google Scholar] [CrossRef]
- Farrag, Y.; Malmir, S.; Montero, B.; Rico, M.; Rodríguez-Llamazares, S.; Barral, L.; Bouza, R. Starch edible films loaded with donut-shaped starch microparticles. LWT 2018, 98, 62–68. [Google Scholar] [CrossRef]
- Hui, A.; Yan, R.; Wang, W.; Wang, Q.; Zhou, Y.; Wang, A. Incorporation of quaternary ammonium chitooligosaccharides on ZnO/palygorskite nanocomposites for enhancing antibacterial activities. Carbohydr. Polym. 2020, 247, 116685. [Google Scholar] [CrossRef] [PubMed]
- Singh, A.; Dubey, A.K. Various biomaterials and techniques for improving antibacterial response. ACS Appl. Bio Mater. 2018, 1, 3–20. [Google Scholar] [CrossRef]
- Espitia, P.J.P.; Soares, N.d.F.F.; dos Reis Coimbra, J.S.; de Andrade, N.J.; Cruz, R.S.; Medeiros, E.A.A. Zinc oxide nanoparticles: Synthesis, antimicrobial activity and food packaging applications. Food Bioprocess Technol. 2012, 5, 1447–1464. [Google Scholar] [CrossRef]
- Jebel, F.S.; Almasi, H. Morphological, physical, antimicrobial and release properties of ZnO nanoparticles-loaded bacterial cellulose films. Carbohydr. Polym. 2016, 149, 8–19. [Google Scholar] [CrossRef]
- Bhaisare, M.L.; Wu, B.S.; Wu, M.C.; Khan, M.S.; Tseng, M.H.; Wu, H.F. MALDI MS analysis, disk diffusion and optical density measurements for the antimicrobial effect of zinc oxide nanorods integrated in graphene oxide nanostructures. Biomater. Sci. 2016, 4, 183–194. [Google Scholar] [CrossRef]
- Barbosa, N.S.; Lima, E.R.; Tavares, F.W. The electrostatic behavior of the bacterial cell wall using a smoothing function to describe the charge-regulated volume charge density profile. Colloids Surf. B Biointerfaces 2015, 134, 447–452. [Google Scholar] [CrossRef]
- Arakha, M.; Saleem, M.; Mallick, B.C.; Jha, S. The effects of interfacial potential on antimicrobial propensity of ZnO nanoparticle. Sci. Rep. 2015, 5, 9578. [Google Scholar] [CrossRef]
- Galli, R.; Hall, M.C.; Breitenbach, E.R.; Colpani, G.L.; Zanetti, M.; de Mello, J.M.M.; Silva, L.L.; Fiori, M.A. Antibacterial polyethylene-Ethylene vinyl acetate polymeric blend by incorporation of zinc oxide nanoparticles. Polym. Test. 2020, 89, 106554. [Google Scholar] [CrossRef]

| Sample | XRD | Zetasizer Nano ZS | |||
|---|---|---|---|---|---|
| Lattice Constant (Å) | Crystal Size (nm) | Average Size (nm) | Zeta Potential (mV) | ||
| a | c | ||||
| ZP0 | 3.253 | 5.213 | 95.08 ± 5.52 a | 198.23 ± 7.22 c | 17.50± 0.46 d |
| ZP1 | 3.253 | 5.213 | 84.00 ± 6.90 c | 236.95 ± 6.86 b | 22.63 ± 0.31 c |
| ZP2 | 3.253 | 5.213 | 92.96 ± 5.76 ab | 262.69 ± 5.54 a | 24.77 ± 0.31 b |
| ZP3 | 3.253 | 5.213 | 89.85 ± 8.06 bc | 246.20 ± 5.69 a | 25.87 ± 0.55 a |
| Sample | Thickness (mm) | Moisture Content (%) | Water Solubility (%) | Water Vapor Permeability (g·m/m2·s·Pa) |
|---|---|---|---|---|
| CS | 0.174± 0.001 c | 19.47 ± 0.32 a | 34.76 ± 0.78 a | 5.32 ± 0.15 a |
| CS/ZP0 | 0.182 ± 0.002 b | 16.68 ± 0.25 d | 27.68 ± 0.81 b | 4.59 ± 0.52 b |
| CS/ZP1 | 0.186 ± 0.003 ab | 18.41 ± 0.38 b | 26.58 ± 0.75 c | 4.52 ± 0.33 b |
| CS/ZP2 | 0.186 ± 0.004 ab | 18.17 ± 0.35 bc | 26.30 ± 0.56 c | 4.51 ± 0.35 b |
| CS/ZP3 | 0.188 ± 0.004 a | 17.89 ± 0.41 c | 26.14 ± 0.15 c | 4.49 ± 0.23 b |
| Sample | Mechanical Properties | Inhibitory Diameter (mm) | % Reduction | |||
|---|---|---|---|---|---|---|
| Tensile Strength (MPa) | Elongation % | E. coli | S. aureus | E. coli | S. aureus | |
| CS | 4.71 ± 0.27 c | 96.79 ± 2.11 a | 0.00 ± 0.00 d | 0.00 ± 0.00 d | 0.00 | 0.00 |
| CS/ZP0 | 7.51 ± 0.29 a | 75.19 ± 2.15 b | 8.90 ± 0.10 c | 8.53 ± 0.21 c | 65.76 | 62.71 |
| CS/ZP1 | 6.07 ± 0.13 b | 71.02 ± 1.99 c | 8.93 ± 0.38 c | 8.90 ± 0.20 c | 68.14 | 67.35 |
| CS/ZP2 | 6.11 ± 0.15 b | 70.07 ± 1.38 c | 9.87 ± 0.35 b | 9.80 ± 0.40 b | 71.04 | 68.09 |
| CS/ZP3 | 6.14 ± 0.09 b | 69.86 ± 1.20 c | 12.40 ± 0.46 a | 11.47 ± 0.32 a | 76.15 | 72.36 |
Publisher’s Note: MDPI stays neutral with regard to jurisdictional claims in published maps and institutional affiliations. |
© 2021 by the authors. Licensee MDPI, Basel, Switzerland. This article is an open access article distributed under the terms and conditions of the Creative Commons Attribution (CC BY) license (http://creativecommons.org/licenses/by/4.0/).
Share and Cite
Charoensri, K.; Rodwihok, C.; Wongratanaphisan, D.; Ko, J.A.; Chung, J.S.; Park, H.J. Investigation of Functionalized Surface Charges of Thermoplastic Starch/Zinc Oxide Nanocomposite Films Using Polyaniline: The Potential of Improved Antibacterial Properties. Polymers 2021, 13, 425. https://doi.org/10.3390/polym13030425
Charoensri K, Rodwihok C, Wongratanaphisan D, Ko JA, Chung JS, Park HJ. Investigation of Functionalized Surface Charges of Thermoplastic Starch/Zinc Oxide Nanocomposite Films Using Polyaniline: The Potential of Improved Antibacterial Properties. Polymers. 2021; 13(3):425. https://doi.org/10.3390/polym13030425
Chicago/Turabian StyleCharoensri, Korakot, Chatchai Rodwihok, Duangmanee Wongratanaphisan, Jung A. Ko, Jin Suk Chung, and Hyun Jin Park. 2021. "Investigation of Functionalized Surface Charges of Thermoplastic Starch/Zinc Oxide Nanocomposite Films Using Polyaniline: The Potential of Improved Antibacterial Properties" Polymers 13, no. 3: 425. https://doi.org/10.3390/polym13030425
APA StyleCharoensri, K., Rodwihok, C., Wongratanaphisan, D., Ko, J. A., Chung, J. S., & Park, H. J. (2021). Investigation of Functionalized Surface Charges of Thermoplastic Starch/Zinc Oxide Nanocomposite Films Using Polyaniline: The Potential of Improved Antibacterial Properties. Polymers, 13(3), 425. https://doi.org/10.3390/polym13030425

